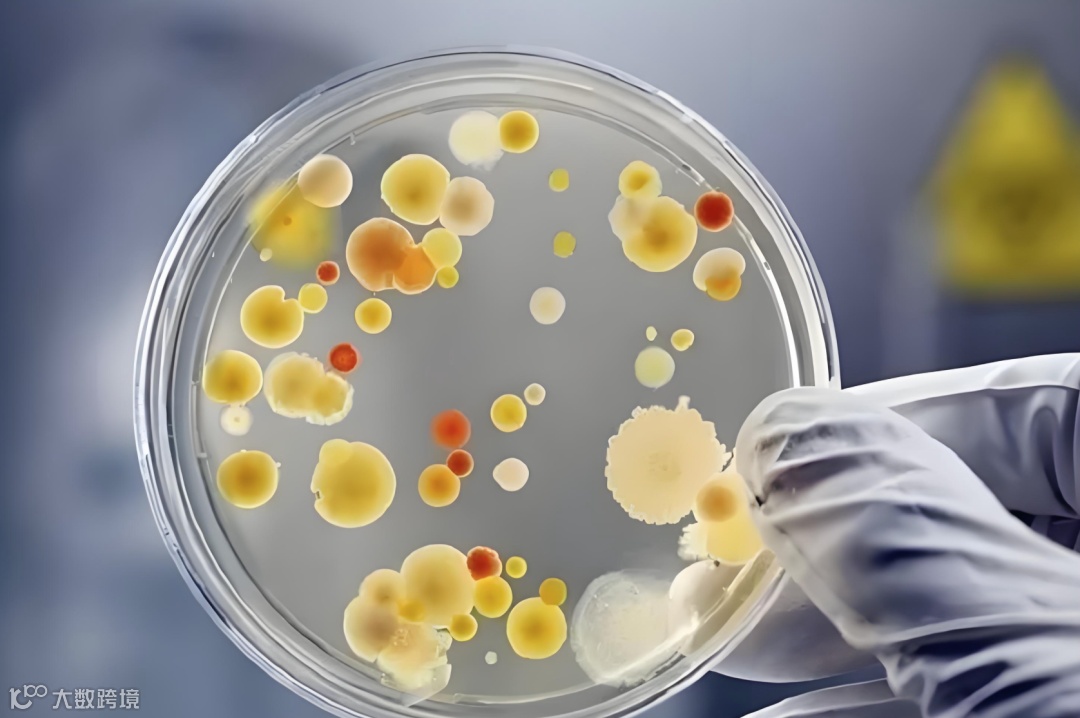

“夏天的食物放冰箱,第二天还能吃吗?” 这大概是每个家庭都会遇到的灵魂拷问。当我们把剩饭剩菜、生鲜水果一股脑塞进冰箱时,可能没意识到 —— 这个看似安全的 “食物保险箱”,其实藏着一个名叫 “李斯特菌” 的隐形威胁。尤其在高温多雨的夏季,冰箱使用频率飙升,更要学会与它 “和平共处”。
李斯特菌:冰箱里的 “耐冷高手”
你或许不知道,有些细菌天生不怕冷。李斯特菌就是其中的 “佼佼者”,它能在 0-4℃的低温环境中存活甚至繁殖,而这正是普通冰箱的冷藏温度。夏季食物丰富,冰箱塞得满满当当,冷空气循环受阻,更给了它可乘之机。
这种细菌常潜伏在这些食物中:
未经彻底加热的肉类(比如冷藏的生肉、半熟牛排)。
即食食品(沙拉、火腿、芝士片)。
冷藏过久的剩菜(超过 24 小时的炒菜、汤羹)。
未清洗的生鲜水果(尤其是表皮有破损的)。
不过不必恐慌,李斯特菌最怕高温 ——70℃以上加热 2 分钟就能被消灭,掌握正确的储存和加热方法,就能轻松抵御。
冰箱使用的 “黄金法则”
1. 分区存放:给食物划清 “楚河汉界”
冰箱不是 “大杂烩”,合理分区能减少细菌交叉污染:
上层:放即食食品(酸奶、剩菜、熟食)
中层:放蔬果(用保鲜盒分装,避免沾水)
下层:放生肉、海鲜(用密封袋包装,避免血水渗漏)。
门架:放调味品(酱料、果汁),这里温度波动大,不适合存放易坏食物。
记住一个原则:生熟分开,就像给食物 “分房间”,避免生肉的细菌 “串门” 到熟食上。
2. 储存时长:给食物设个 “保质期”
别让食物在冰箱里 “常住”,即便是冷藏,也有最佳食用期限:
剩菜:冷藏不超过 24 小时,吃前彻底加热(中心温度达 70℃以上)。
生鲜肉类:冷藏不超过 2 天,超过就分装冷冻
蔬果:绿叶菜 3 天内吃完,胡萝卜、土豆等根茎类可放 1 周。
熟食:真空包装的火腿开封后 3 天内吃完,自制酱肉不超过 5 天。
可以在保鲜盒上贴便签,写上存放日期,像给食物 “发身份证”,过期就果断丢弃。

夏季饮食的 “避坑指南”
1. 取出食物别 “偷懒”
剩菜从冰箱拿出后,别急着直接吃,哪怕是凉菜也要加热到冒热气(比如凉拌黄瓜,放回锅中小火翻炒 10 秒)。
冷冻的肉类提前放冷藏解冻,别用温水泡或直接蒸,避免外层解冻内层还冻着,滋生细菌。
水果从冰箱拿出后,用流动水冲洗 30 秒,别用洗洁精,搓洗表皮即可(尤其是草莓、葡萄这类易残留细菌的)。
2. 冰箱清洁别 “拖延”
每周给冰箱做一次 “大扫除”:
拔掉电源,清空食物,用稀释的白醋(1:10 比例)擦拭内壁(白醋的酸性可抑制细菌)。
抽屉、隔板拿出来用热水冲洗,晾干后再放回。
排水管(冰箱底部的小孔)用棉签蘸酒精擦拭,避免积水滋生细菌。
门封条缝隙用牙刷刷干净,这里最容易藏污纳垢。

这些场景要特别注意
外卖没吃完,放冰箱前要分成小份(避免反复加热),第二天必须彻底加热。
自制的沙拉(比如土豆沙拉、水果沙拉)最好现做现吃,别放冰箱隔夜。
孩子的辅食从冰箱取出后,只加热一次,吃不完就倒掉,别反复加热。
冰淇淋、雪糕开封后及时封口,避免冰箱异味污染。
结语:冰箱是 “助手” 不是 “保险柜”
夏季高温加速食物变质,冰箱只是延缓细菌繁殖的 “缓冲带”,不是万能的 “保鲜神器”。与其依赖冰箱的低温,不如牢记 “少量多次购买、现做现吃、及时清理” 的原则。毕竟,守护家人饮食安全的,从来不是冰冷的机器,而是我们对生活细节的用心。
这个夏天,让冰箱成为健康饮食的好帮手,而非细菌滋生的 “温床”—— 从今天起,给冰箱来一次彻底清洁,给食物贴上 “保质期标签”,让每一餐都吃得安心又放心。
本文为生活常识分享,不涉及医疗建议。若食用后出现不适,建议及时咨询专业机构。
👇点我点我👇

长按图片打开小程序

👆点击图片可购买👆
北京宝丽上元科技发展有限责任公司


